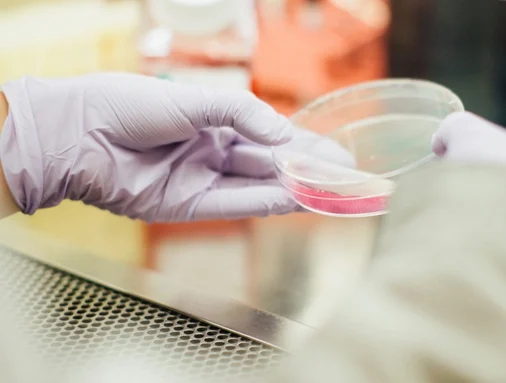

Συμφωνία απόκτησης πλειοψηφικού μεριδίου μετοχών της διεθνούς φαρμακευτικής εταιρείας Synthon, υπέγραψαν η BC Partners και η Goldman Sachs Alternatives με την BC Partners να διατηρεί μειοψηφικό μερίδιο στη Synthon, προκειμένου να υποστηρίξει τη μελλοντική της ανάπτυξη.
Η BC Partners απέκτησε το πλειοψηφικό μερίδιο της Synthon από τους ιδρυτές της εταιρείας το 2019 μέσω διμερούς συναλλαγής. Αξιοποιώντας την τεχνογνωσία στον τομέα των φαρμακευτικών και γενόσημων φαρμάκων, που αποκτήθηκε μέσω προηγούμενων επενδύσεων όπως η Pharmathen, η BC Partners μπόρεσε να οδηγήσει σε σημαντική οργανική ανάπτυξη και γεωγραφική επέκταση με έμφαση στην εμπορική αριστεία, την Ε&Α, τη διαφοροποίηση της τεχνολογίας και τη λειτουργική υπεροχή. Από την αρχική επένδυση πριν από πέντε χρόνια, η Synthon έχει υπερδιπλασιάσει το EBITDA και έχει παγιώσει την ηγετική της θέση στον κλάδο.
Οι όροι της συναλλαγής δεν αποκαλύφθηκαν.